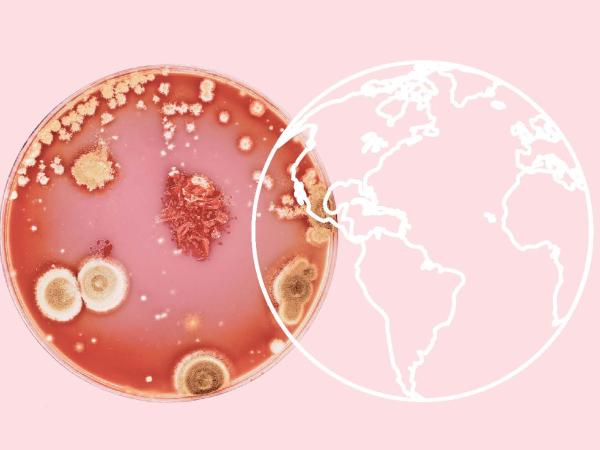
De stille pandemie van de antibioticaresistentie

In this fascinating book, science author Toon Verlinden invites you to join him on a journey of discovery through the marvellous world of solar eruptions, volcanoes, viruses, and near-Earth asteroids.
Subscribe to our newsletter
- Be the first to know about our grant deadlines
- Discover the latest supported projects
- Follow all the latest investigative journalism in Flanders